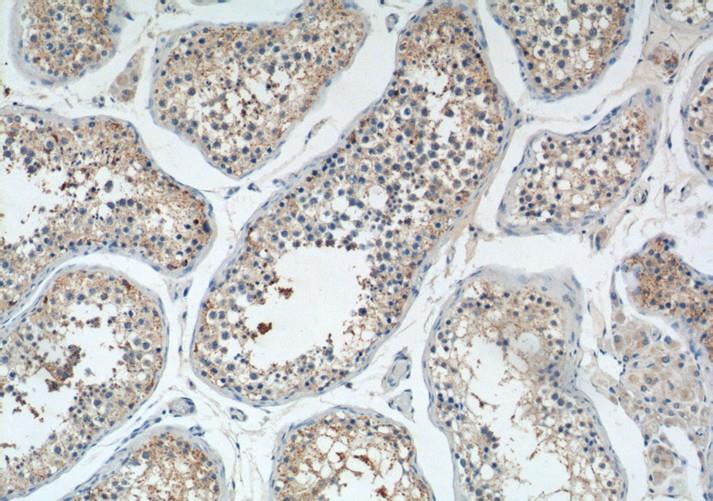
使用PIWIL2抗体对石蜡包埋人睾丸组织切片进行免疫组织化学分析 使用PIWIL2抗体对石蜡包埋人睾丸组织切片进行免疫组织化学分析

PIWIL2抗体是一种可特异性识别小鼠来源的PIWIL2蛋白, PIWIL2抗体的特异性抗原位于mouse物种的PIWIL2的内部区域内的氨基酸157-191之间。PIWIL2抗体可由小鼠PIWIL2重组蛋白作为免疫原制备而成,在生物化学基础研究领域中有一定的应用。

图1 PIWIL2抗体检测小鼠胚胎睾丸蛋白印迹
背景介绍
图2 使用PIWIL2抗体对石蜡包埋人睾丸组织切片进行免疫组织化学分析
PIWIL2抗体可特异性识别小鼠与大鼠来源的PIWIL2蛋白,该蛋白属于Argonaute蛋白家族,在生殖系干细胞的发育与维持中发挥功能。它在精子发生过程中通过抑制转座元件的活化发挥核心作用,从而保障生殖系遗传完整性,并在精母细胞减数分裂分化、生殖细胞分化及精原干细胞自我更新中起关键调控作用,其在卵母细胞中的存在表明该蛋白可能在雌性卵子发生过程中承担相似功能。值得注意的是,PIWIL2抗体的应用为研究上述机制提供了重要工具,该蛋白可间接调控PDGFRB、SLC2A1、ITGA6、GJA7、THY1、CD9和STRA8等基因表达,其表达受抑制时可阻碍肿瘤细胞生长,而过量表达则通过抑制细胞凋亡、促进增殖途径发挥癌基因功能。
制备方法
有研究人员报道了制备PIWIL2抗体并鉴定其特异性的方法,研究人员初步探讨其在人正常及肿瘤组织中的分布。方法:人工合成特异性PIWIL2多肽,以马来酰胺活化匙孔血蓝蛋白(Keyhole limpet hemocyanin,KLH)为载体构建多肽免疫原,致敏大白兔,制备兔抗人PIWIL2多克隆抗体。亲和层析法纯化抗体,ELISA和Western 印迹鉴定特异性,人组织芯片行PIWIL2的免疫组化研究。结果:通过构建PIWIL2多肽-KLH载体复合物致敏大白兔,制备出PIWIL2抗体。[1]
生物应用
PIWIL2抗体能够特异性检测小鼠的PIWIL2蛋白,果蝇的piwi基因属于一个进化上保守的新基因类别(piwi/Argonaute家族),该家族在无脊椎动物的生殖与干细胞发育中不可或缺,而其两个哺乳动物成员MIWI和PIWIL2(即MILI)正是小鼠精子发生的关键调控因子,可通过PIWIL2抗体进行特异性检测。
参考文献
[1] 朱风尚等.抗PIWIL2蛋白多克隆抗体的制备、鉴定及初步应用[J].第二军医大学学报, 2008, 29:4.